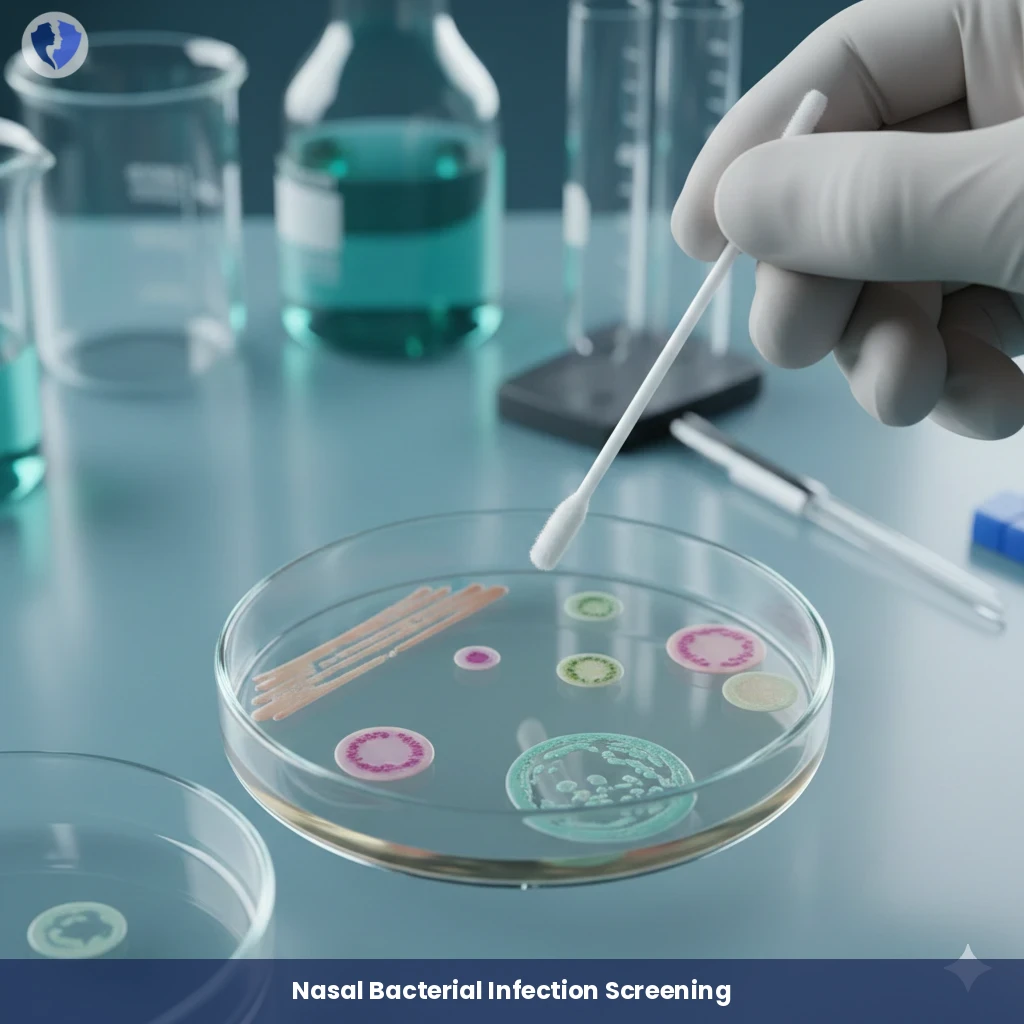
Nose Swab Culture Test - Nose Swab Culture and Sensitivity

Service Details
Nose Swab Culture Test - Nose Swab Culture and Sensitivity
A diagnostic microbiological examination in which a sample is collected from the nasal lining (usually from the anterior part of the nostrils or nasopharynx) using a sterile swab. The sample is cultured on selective, enriched media for the initial isolation of bacteria and fungi. After incubation, the pathogenic bacteria (such as Staphylococcus aureus, Streptococcus pneumoniae) are identified, and an antisusceptibility test (antibiogram) is performed to guide optimal drug therapy.